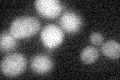
YNL242W
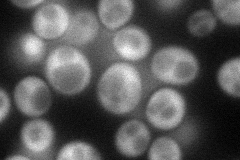
YNL242W
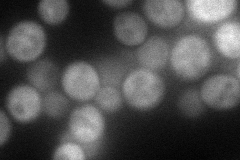
YNL242W
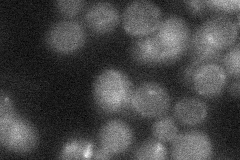
YNL242W
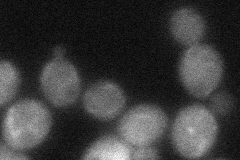
YNL242W

View description
Peripheral membrane protein required for vesicle formation during autophagy, pexophagy, and the cytoplasm-to-vaucole targeting (Cvt) pathway; involved in Atg9p cycling between the phagophore assembly site and mitochondria
Localization:
Intensity:
Fold change:
Significance:
-
C’ GFP library in SD
below threshold16.56 -
N' NOP1pr-GFP in SD
cytosol70.2406 -
N' TEF2pr-mCherry in SD
cytosol57.9017 -
N' NATIVEpr-GFP in SD
below threshold18.6658 -
N' TEF2pr-VC and Cyto-VN in SD
cytosol32.8992 -
C’ GFP library in SD+DTT

technical problem0N/ANo -
C’ GFP library in SD+H2O2

cytosol20.541.24No -
C’ GFP library in Starvation Media

cytosol16.380.98No -
C’ GFP library on the background of Pup2-DaMP

below threshold -
C’ GFP library on the background of CCT mutant

below threshold15.93890.962426No
